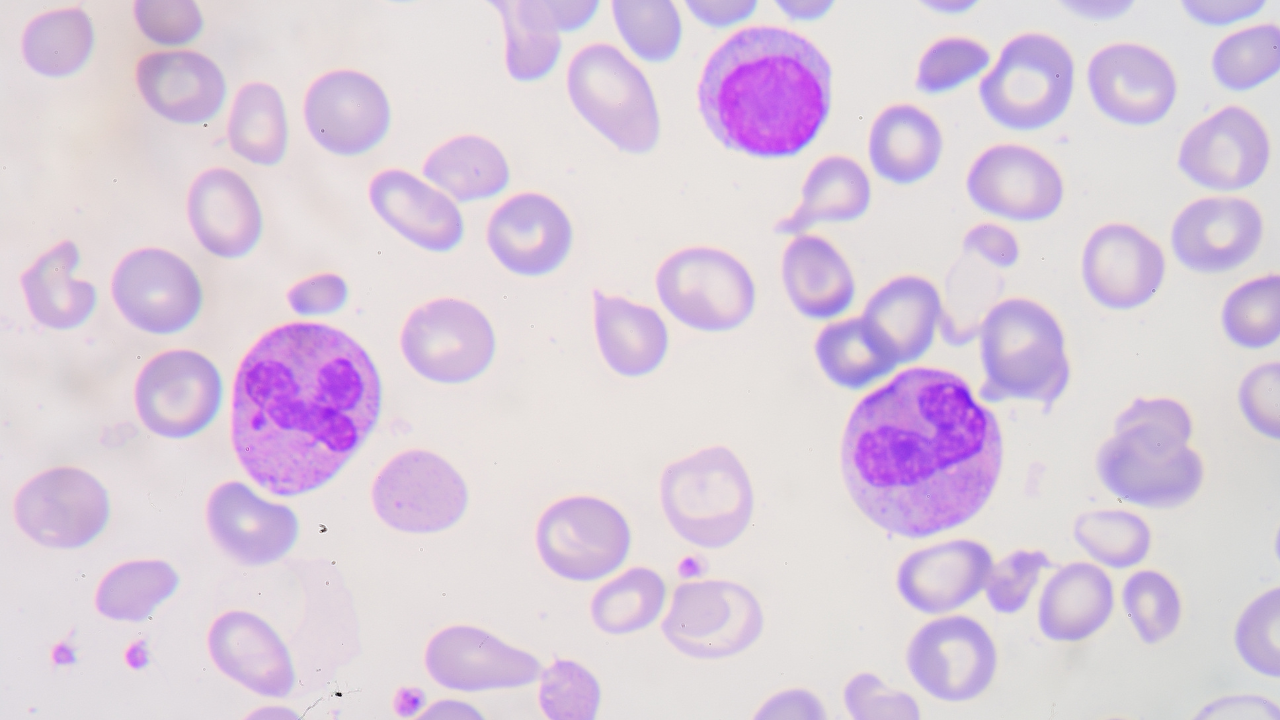
Khám sàng lọc Thalassemia là gì?

Thalassemia (tan máu bẩm sinh) là một trong những bệnh di truyền phổ biến nhưng lại thường bị bỏ sót do người mang gen không có biểu hiện rõ ràng. Chính vì vậy, khám sàng lọc Thalassemia ngày càng được khuyến khích như một bước quan trọng trong chăm sóc sức khỏe sinh sản. Việc hiểu rõ khám sàng lọc Thalassemia là gì và ai nên thực hiện sẽ giúp mỗi người chủ động hơn trong việc bảo vệ sức khỏe cho bản thân và thế hệ tương lai.
Khám sàng lọc Thalassemia là gì?
Khám sàng lọc Thalassemia nhằm xác định một người có mang gen bệnh Thalassemia (tan máu bẩm sinh) hay không, kể cả khi chưa có biểu hiện lâm sàng. Việc sàng lọc đóng vai trò rất quan trọng trong chăm sóc sức khỏe sinh sản, đặc biệt với các cặp đôi chuẩn bị kết hôn, phụ nữ mang thai hoặc những trường hợp có kế hoạch sinh con bằng thụ tinh trong ống nghiệm.
Thalassemia là bệnh di truyền lặn trên nhiễm sắc thể thường. Điều này có nghĩa là người mang gen bệnh vẫn có thể sống khỏe mạnh bình thường, nhưng nếu cả bố và mẹ cùng mang gen, nguy cơ sinh con mắc bệnh sẽ tăng cao. Trẻ mắc Thalassemia thể nặng có thể bị thiếu máu nghiêm trọng, chậm phát triển thể chất và trí tuệ, thậm chí phải truyền máu định kỳ suốt đời hoặc ghép tủy xương để duy trì sự sống.
Khám sàng lọc Thalassemia giúp phát hiện sớm người mang gen bệnh, từ đó tạo điều kiện để bác sĩ tư vấn di truyền cụ thể và chính xác. Nhờ có thông tin đầy đủ, các cặp vợ chồng có thể chủ động đưa ra quyết định phù hợp trong việc mang thai và sinh con. Đây được xem là biện pháp hiệu quả nhằm phòng ngừa trẻ sinh ra mắc tan máu bẩm sinh, góp phần bảo vệ sức khỏe thế hệ tương lai và giảm gánh nặng lâu dài cho gia đình cũng như xã hội.
Khi nào nên khám và sàng lọc Thalassemia?
Việc sàng lọc gen bệnh tan máu bẩm sinh Thalassemia nên được thực hiện sớm và đúng thời điểm để chủ động phòng ngừa nguy cơ sinh con mắc bệnh. Tùy từng giai đoạn cuộc sống, mỗi người có thể lựa chọn thời điểm khám phù hợp nhằm đạt hiệu quả cao nhất.
Trước khi kết hôn hoặc trước khi mang thai
Trước khi kết hôn hoặc trước khi mang thai được xem là thời điểm lý tưởng để sàng lọc Thalassemia. Thông qua các xét nghiệm máu cơ bản và điện di huyết sắc tố, bác sĩ có thể phát hiện người mang gen bệnh dù chưa có triệu chứng. Nếu cả hai vợ chồng cùng mang gen, nguy cơ sinh con mắc bệnh có thể lên tới 25% ở mỗi lần mang thai. Khi đó, tư vấn di truyền sẽ giúp cặp đôi hiểu rõ nguy cơ và lựa chọn phương án sinh con an toàn.

Trong thai kỳ
Trong thai kỳ, đặc biệt là 3 tháng đầu, thai phụ chưa từng sàng lọc trước đó nên thực hiện xét nghiệm càng sớm càng tốt. Trường hợp cả bố và mẹ đều mang gen bệnh, bác sĩ sẽ chỉ định các phương pháp chẩn đoán trước sinh phù hợp nhằm đánh giá chính xác tình trạng của thai nhi.

Khi thực hiện thụ tinh trong ống nghiệm
Khi thực hiện thụ tinh trong ống nghiệm, sàng lọc Thalassemia là bước rất quan trọng. Với các cặp đôi cùng mang gen bệnh, xét nghiệm di truyền tiền làm tổ giúp lựa chọn phôi khỏe mạnh, từ đó giảm thiểu nguy cơ trẻ sinh ra mắc tan máu bẩm sinh.
Tầm quan trọng của việc sàng lọc Thalassemia sớm
Sàng lọc Thalassemia sớm đóng vai trò quan trọng:
Phát hiện sớm người mang gen bệnh Thalassemia
Thalassemia là bệnh di truyền khá phổ biến tại Việt Nam, với hàng triệu người mang gen bệnh nhưng không có biểu hiện rõ ràng. Việc sàng lọc sớm giúp phát hiện chính xác người mang gen, đặc biệt trước hôn nhân, trước khi mang thai hoặc trong thai kỳ. Khi xác định được nguy cơ di truyền, các cặp đôi sẽ có cơ hội được tư vấn di truyền đầy đủ, hiểu rõ khả năng ảnh hưởng đến con và chủ động đưa ra quyết định phù hợp cho kế hoạch sinh sản.

Phòng ngừa sinh con mắc Thalassemia thể nặng
Trẻ mắc Thalassemia thể nặng thường phải truyền máu và thải sắt định kỳ suốt đời hoặc cần ghép tủy để duy trì sự sống. Tình trạng này ảnh hưởng nghiêm trọng đến sức khỏe, sự phát triển thể chất, tinh thần và tuổi thọ của trẻ. Sàng lọc Thalassemia sớm được xem là biện pháp hiệu quả nhất nhằm giảm nguy cơ sinh con mắc bệnh, bảo vệ tương lai lâu dài cho trẻ.
Giảm gánh nặng điều trị cho gia đình và xã hội
Chi phí điều trị Thalassemia thể nặng rất lớn và kéo dài nhiều năm, gây áp lực tài chính và tâm lý cho gia đình. So với điều trị, việc sàng lọc và phòng ngừa có chi phí thấp hơn rất nhiều, đồng thời giúp giảm gánh nặng cho hệ thống y tế và xã hội.
Nâng cao chất lượng dân số, bảo vệ thế hệ tương lai
Sàng lọc Thalassemia không chỉ mang ý nghĩa cá nhân mà còn có giá trị cộng đồng. Việc phát hiện và phòng ngừa sớm góp phần xây dựng thế hệ trẻ khỏe mạnh, giảm thiểu bệnh di truyền và nâng cao chất lượng dân số trong tương lai.
Hy vọng qua nội dung bài viết bạn đã có thêm thông tin khám sàng lọc thalassemia là gì. Khám sàng lọc Thalassemia đóng vai trò quan trọng trong việc phát hiện sớm người mang gen bệnh và phòng ngừa sinh con mắc tan máu bẩm sinh thể nặng. Việc thực hiện sàng lọc đúng thời điểm, đặc biệt với các cặp đôi chuẩn bị kết hôn, phụ nữ mang thai hoặc người có kế hoạch sinh con, sẽ giúp đưa ra những quyết định phù hợp và an toàn hơn. Chủ động sàng lọc không chỉ bảo vệ hạnh phúc gia đình mà còn góp phần nâng cao chất lượng dân số và sức khỏe cộng đồng.
:format(webp)/Desktop_70c81619bb.png)
:format(webp)/467434554_545745841560409_1066418224364723785_n_560a494f9c.png)
/kham_sang_loc_truoc_tiem_hieu_dung_de_tiem_chung_an_toan_043880673b.png)
/6_884153be83.png)
/xet_nghiem_syphilis_la_gi_cac_loai_xet_nghiem_syphilis_va_quy_trinh_thuc_hien_f2bb750eb0.jpg)
/khi_nao_can_thuc_hien_xet_nghiem_do_nong_do_enzyme_aldolase_1_d8e18f9717.png)
/alpha_1_antitrypsin_la_gi_1_21b8277052.png)